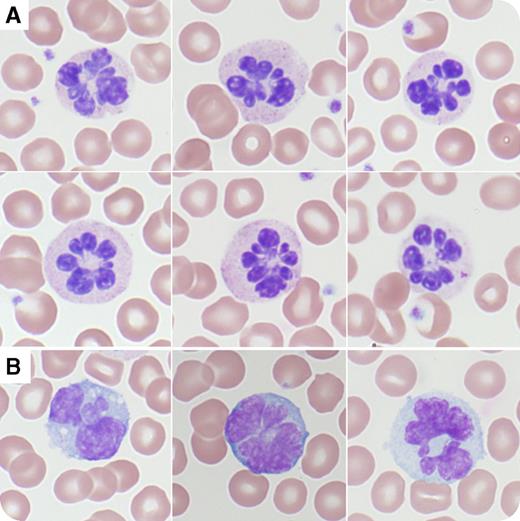
A 39-year-old man with a history of intravenous drug abuse and hepatitis C virus infection was found unresponsive on the street in Tucson, Arizona. His temperature was 41.8°C and he was tachycardic, hypotensive, and hypoxemic. A complete blood count showed white blood cell count of 17.8 × 109/L, red blood cell count of 5.21 × 1012/L, hemoglobin level of 164 g/L, mean corpuscular volume of 97.6 fL, red cell distribution width of 13.8%, and platelet count of 386 × 109/L. A urine drug screen detected opiates and amphetamines. The peripheral blood showed absolute neutrophilia with a shift to immaturity and botryoid-type hypersegmentation of the neutrophils (65% affected; panel A, original magnification ×100; Wright-Giemsa stain), monocytes (panel B, original magnification ×100; Wright-Giemsa stain), and lymphocytes. These morphologic features returned to normal 24 hours after hydration and cooling. / Although neutrophil hypersegmentation can be seen in vitamin B12 and folate deficiencies, heat shock, or amphetamine overdose, the morphologic features differ depending on the underlying cause. In nutritional deficiencies, the number of segments is increased up to 5, 6, and rarely 7. Conversely, in heat shock and amphetamine overdose, the neutrophils, monocytes, and lymphocytes are hypersegmented up to 9 lobes emanating from a single centriole with radial segmentation: the so-called botryoid type. Leukocyte morphology and mean corpuscular volume can help differentiate the diagnosis.

A 39-year-old man with a history of intravenous drug abuse and hepatitis C virus infection was found unresponsive on the street in Tucson, Arizona. His temperature was 41.8°C and he was tachycardic, hypotensive, and hypoxemic. A complete blood count showed white blood cell count of 17.8 × 109/L, red blood cell count of 5.21 × 1012/L, hemoglobin level of 164 g/L, mean corpuscular volume of 97.6 fL, red cell distribution width of 13.8%, and platelet count of 386 × 109/L. A urine drug screen detected opiates and amphetamines. The peripheral blood showed absolute neutrophilia with a shift to immaturity and botryoid-type hypersegmentation of the neutrophils (65% affected; panel A, original magnification ×100; Wright-Giemsa stain), monocytes (panel B, original magnification ×100; Wright-Giemsa stain), and lymphocytes. These morphologic features returned to normal 24 hours after hydration and cooling.
Although neutrophil hypersegmentation can be seen in vitamin B12 and folate deficiencies, heat shock, or amphetamine overdose, the morphologic features differ depending on the underlying cause. In nutritional deficiencies, the number of segments is increased up to 5, 6, and rarely 7. Conversely, in heat shock and amphetamine overdose, the neutrophils, monocytes, and lymphocytes are hypersegmented up to 9 lobes emanating from a single centriole with radial segmentation: the so-called botryoid type. Leukocyte morphology and mean corpuscular volume can help differentiate the diagnosis.
A 39-year-old man with a history of intravenous drug abuse and hepatitis C virus infection was found unresponsive on the street in Tucson, Arizona. His temperature was 41.8°C and he was tachycardic, hypotensive, and hypoxemic. A complete blood count showed white blood cell count of 17.8 × 109/L, red blood cell count of 5.21 × 1012/L, hemoglobin level of 164 g/L, mean corpuscular volume of 97.6 fL, red cell distribution width of 13.8%, and platelet count of 386 × 109/L. A urine drug screen detected opiates and amphetamines. The peripheral blood showed absolute neutrophilia with a shift to immaturity and botryoid-type hypersegmentation of the neutrophils (65% affected; panel A, original magnification ×100; Wright-Giemsa stain), monocytes (panel B, original magnification ×100; Wright-Giemsa stain), and lymphocytes. These morphologic features returned to normal 24 hours after hydration and cooling.
Although neutrophil hypersegmentation can be seen in vitamin B12 and folate deficiencies, heat shock, or amphetamine overdose, the morphologic features differ depending on the underlying cause. In nutritional deficiencies, the number of segments is increased up to 5, 6, and rarely 7. Conversely, in heat shock and amphetamine overdose, the neutrophils, monocytes, and lymphocytes are hypersegmented up to 9 lobes emanating from a single centriole with radial segmentation: the so-called botryoid type. Leukocyte morphology and mean corpuscular volume can help differentiate the diagnosis.
For additional images, visit the ASH IMAGE BANK, a reference and teaching tool that is continually updated with new atlas and case study images. For more information visit http://imagebank.hematology.org.